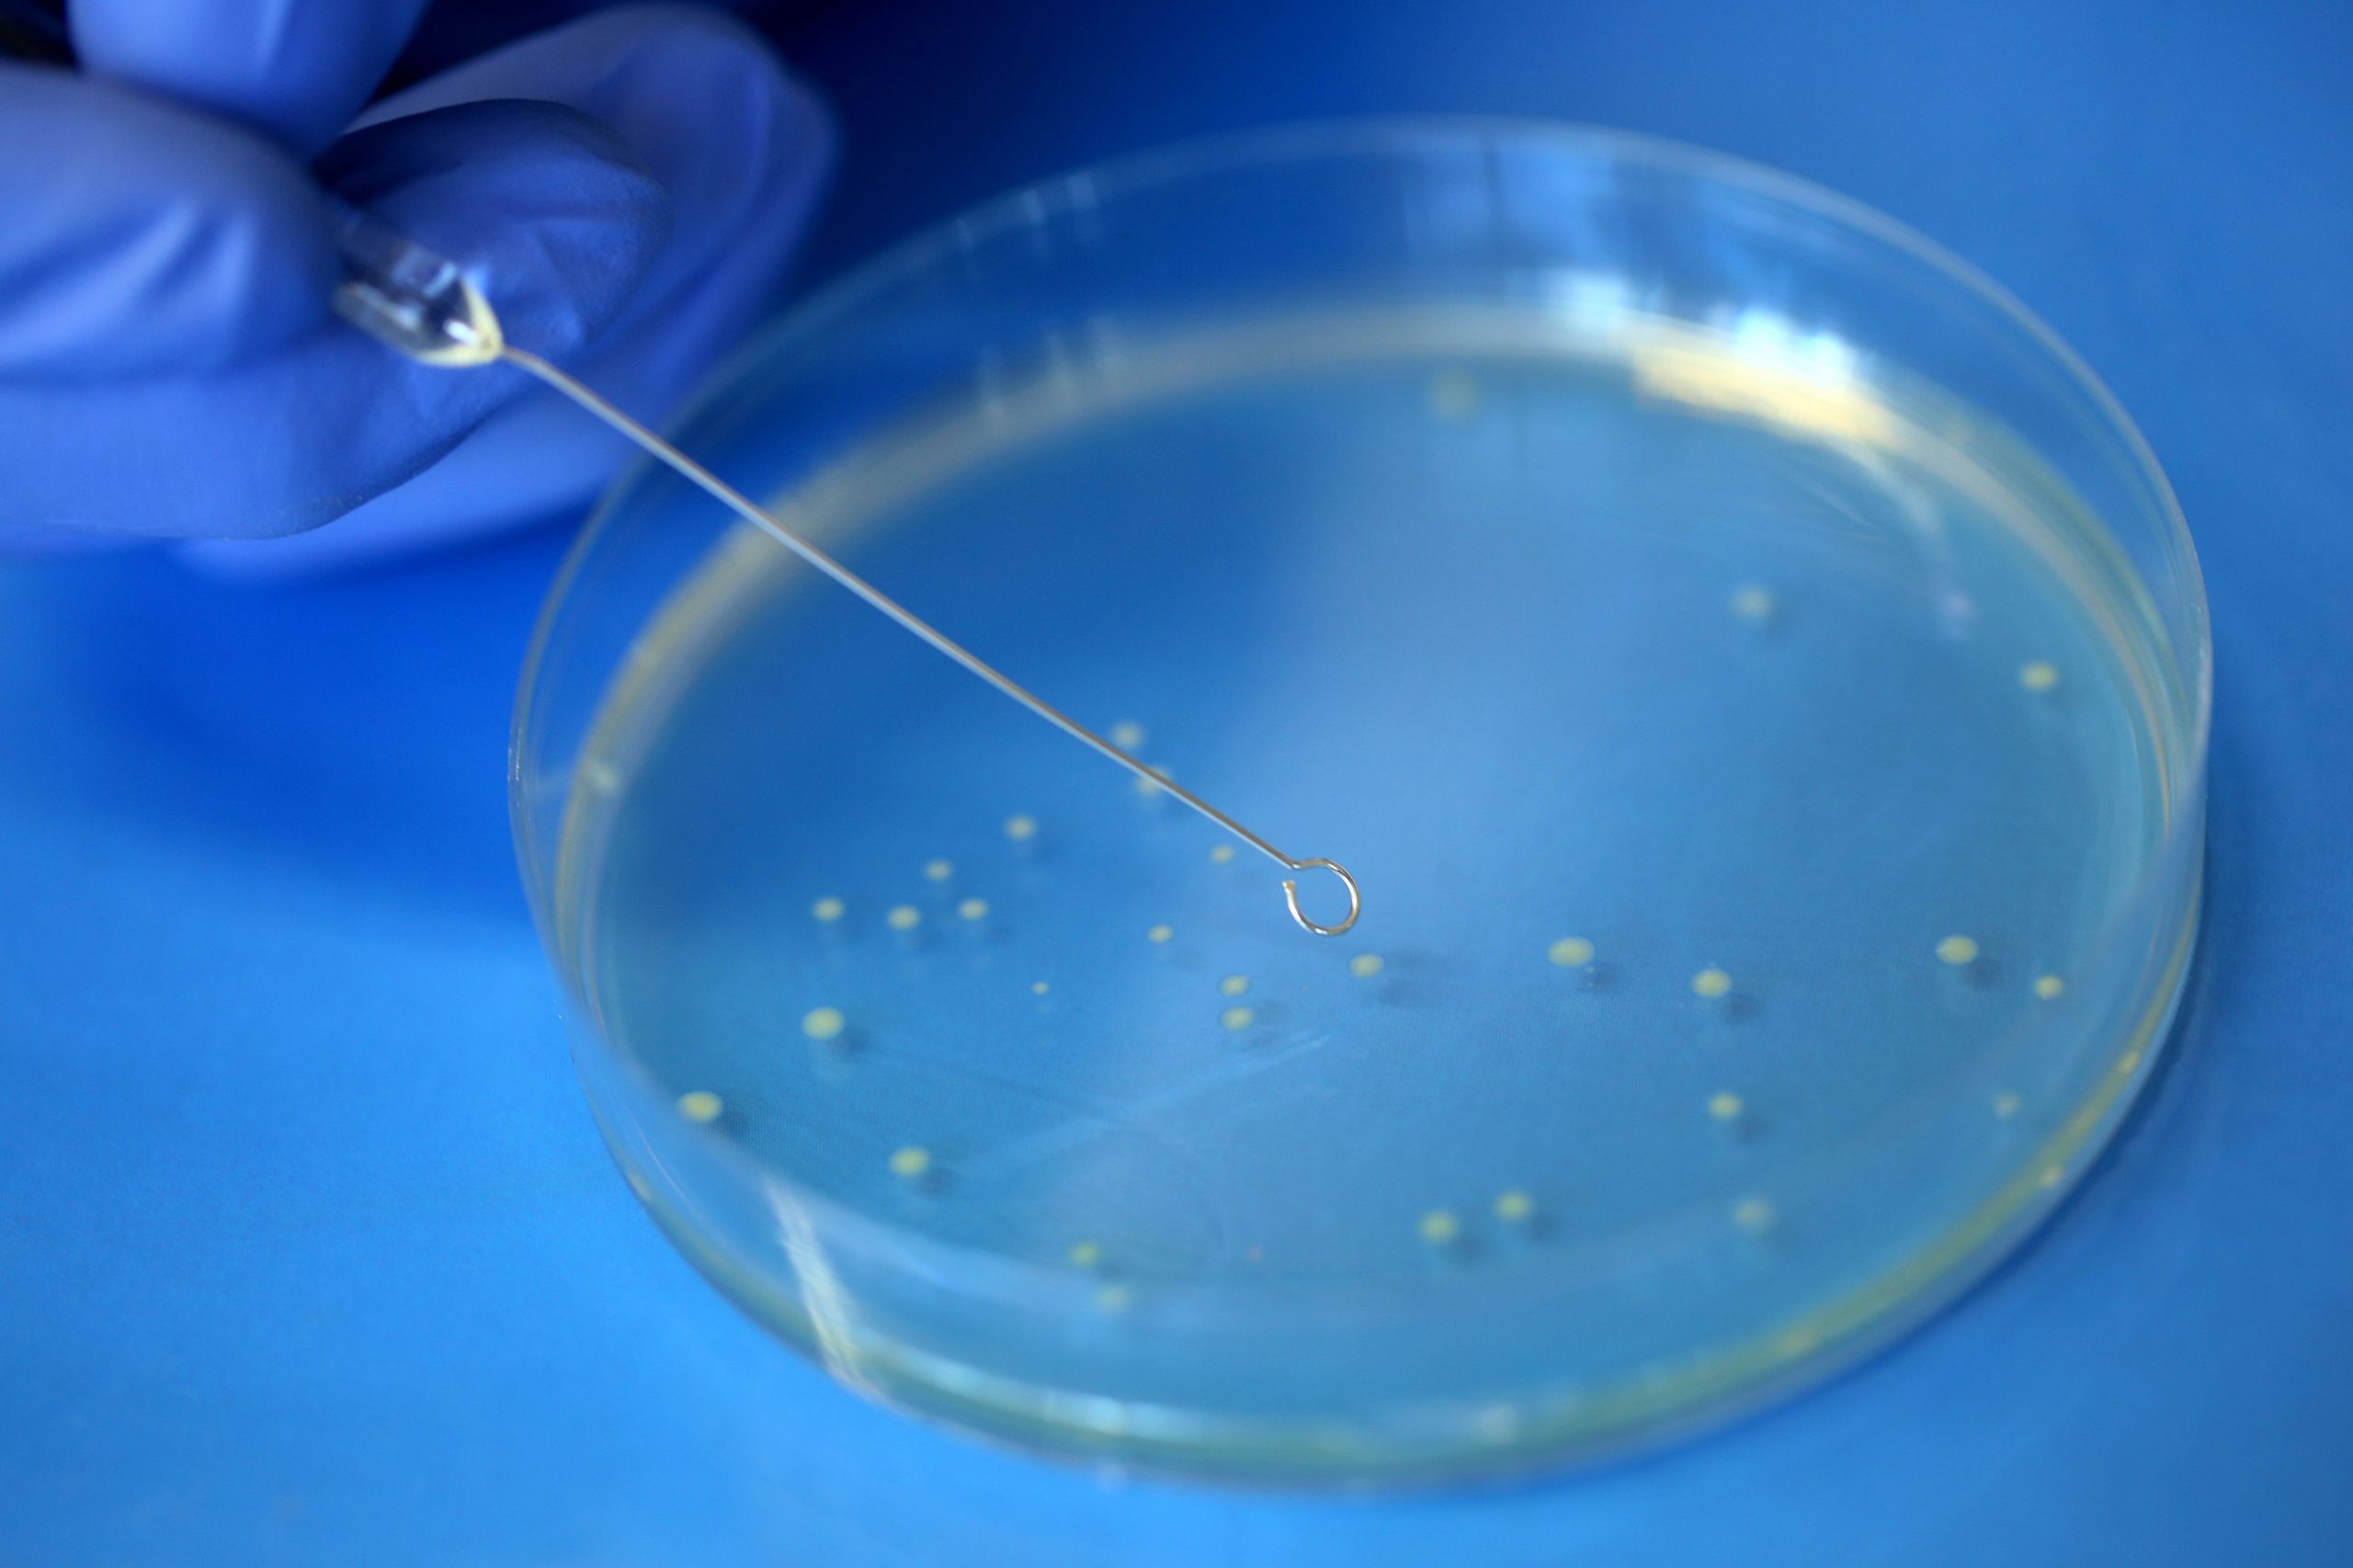
Biocentar10 Scaled

Central laboratory (CL) is a core facility designed to offer a range of process development services necessary to develop and commercialize new products.
CL comprises 6 specialized labs (~ 600 square meters total) with state-of-the art equipment, storage areas, washing and sterilization room and offices for permanent staff.
Microbiology laboratory staff:
Maja Marinović, PhD, Head of Microbiology laboratory, e-mail: maja.marinovic@biocentre.hr
Matea Zelenika, M.Eng., Associate, e-mail: matea.zelenika@biocentre.hr
Mateja Lozančić, PhD, Senior Associate, e-mail: mateja.lozancic@biocentre.hr
Laboratory services:
Recombinant protein production and purification (µg to mg scale), production process development for proteins, biopharmaceuticals and biosimilars. We perform a variety of microbiological tests on finished products or products in development and offer bacteria and yeasts cell propagation and banking.
Recombinant protein production services include:
- Construction and optimization of plasmid vectors with inserted DNA of interest. Multiplication of the vector in bacterial host cells. Isolation and purification of the vector, followed by quantitative (spectrophotometric or fluorescent based) and qualitative (electrophoretic separation for integrity and purity testing; DNA sequence analysis) analyses.
- Transformation of the producer strain cells (bacteria or yeast) with the vector and selection of optimal producers.
- Configuration and optimization of production parameters for optimal biomass and/or recombinant protein yield. Production parameters are optimized through serial fermentations in 0,5 L bioreactors under varying conditions of media composition, temperature, aeration, stirring, pH and related parameters.
- Production scale-up to 2 L and/or 30 L bioreactors.
- Purification of intracellularly (mechanical and/or chemical cell lysis) or extracellularly expressed recombinant proteins. Further purification and isolation steps are offered as part of our Downstream processing laboratory Protein characterization and other protein structure analyses can be performed by our Bioanalytical laboratory II – Proteomics.
We also offer production of the microbial biomass or other microbial metabolites such as different polymers, organic acids or other products of interest.
Analyses of components and final products include:
- Detection of microorganisms in components or final product as part of quality control or for resolving contamination issues in production processes.
- Microbial enumeration and quality tests of products by conventional microbiology or by molecular biology (PCR and qPCR) techniques.
- Method development/optimization for product quality testing, testing of the product influence on microbial growth, microbial stability testing of the product or similar tests.
Some of the microbiological services offered:
- Development / optimization of method for microbial quality testing
- Development / optimization of microbial assay of antibiotics
- Adhesion of bacterial on human cells testing (preliminary tests of pre-/pro-/postbiotics)
- Microbial analysis of the beer (detection of most common and/or identification of individual beer spoilers)
INSTRUMENTS AND EQUIPMENT
Bioreactors
- BIOSTAT Qplus 12 x 0,5 L MO, BIOSTAT B Twin 2 L MO, BIOSTAT Cplus 30 L MO, Sartorius
Homogenizers
- Panda Plus high pressure homogenizer, Gea Niro Soavi
- Bandelin ultrasonic homogenizer, Sonoplus
PCR and qPCR
- SimpliAmp PCR thermocycler, Applied Biosystems
- AriaMx Real-Time PCR System, Agilent Technologies
Quantitative measurement of concentration
- NanoDrop One spectrophotometer, Thermo Scientific
- Qubit 4 Fluorometer, Thermo Fisher Scientific
Centrifugation and sample preparation equipment
- Continuous flow centrifuge, Sorval Stratos
- Innova S44i incubator shaker, Eppendorf
more available equipment.
Cell biology laboratory staff:
Dora Markulin, PhD, Head of laboratory, e-mail: dora.markulin@biocentre.hr
Mihaela Kordun, MSc in molecular biology, Associate, e-mail: mihaela.kordun@biocentre.hr
Laboratory services:
Cultivation and storage of cell lines, as well as process development and conduct of analyses using molecular biology methods (e.g. PCR, qPCR, flow cytometry).

Cell culture cultivation and molecular biology tests include:
Cultivation and storage of cells
- Culturing human and animal cell lines (adherent cell lines and cell lines in suspension)
- Storage of human and animal cell lines in liquid nitrogen
Analysis and characterization of cells
- Mycoplasma testing of cells
- Analysis of heterogeneous cell populations
- Identification of specific cell type
- Treating cells with compounds of interest
Molcecular biology techniques
- Isolation, detection and quantification of DNA and RNA
- PCR and qPCR analysis of DNA and RNA
Functional and biochemical cell assays
- Cell viability/cytotoxicity assays
- Apoptosis assays
- Cell cycle arrest assays
- Cell differentiation analysis
- Quantification of soluble substances in cells
- Assessment of prooxidative effects of substances
INSTRUMENTS AND EQUIPMENT
PCR and qPCR instruments
- SimpliAmp Thermal Cycler, Applied Biosystems
- AriaMX qPCR, Agilent Technologies
Flow cytometer and instruments for cell analyses
- BD FACSVerse flow cytometer, BD Biosciences
- Countess 3 Automated Cell Counter, Thermo Fisher Scientific
- Plate Chameleon V microplate reader, Hidex
Microscope
- MCX1600 inverted microscope, Micros Austria
Equipment for cell culture cultivation
- CO₂ incubator for cell culture, Binder
- EuroClone S@femate 1.2 microbiological safety cabinet, BioAir
Equipment for centrifugation and cryogenic storage
- Sorvall Centrifuge Stratos, Thermo Fisher Scientific
- Liquid nitrogen storage tank, Arpege 110, Air liquid
Downstream processing laboratory staff:
Ana Smolko, PhD, Senior Associate, e-mail: ana.smolko@biocentre.hr
Marija Ivić, M. Sc., Associate, e-mail: marija.ivic@biocentre.hr
Laboratory services:
Biological material downstream processing, such as isolation of biomolecules, native and recombinant proteins from various samples. Services include process optimization on a laboratory scale, and transfer to a pilot production scale.

Processing of complex mixtures
- Using preparative liquid chromatography biomolecules or small molecules are separated from complex mixtures. Depending on the physiochemical properties of both, the sample and the analyte, an appropriate type of liquid chromatography is used – e.g. ion exchange chromatography, size exclusion chromatography, affinity chromatography, reversed – phase chromatography, etc.
- Complex mixtures can be fractionated based on a specific property, e.g. ionic strength, molecule size, and the obtained fractions can be analyzed and characterized further.
Diafiltration and concentrating
- Tangential flow filtration is used to concentrate a sample, or to exchange a buffer in large-volume samples (from half a liter to several tens of liters).
Processing on different scales
- The Laboratory is equipped to accommodate processing on different scales – from laboratory scale to a pilot production scale. Downstream processing procedure is developed and optimized on a laboratory scale, and then scaled up to a desired volume.
Process optimization
- The laboratory offers a service for optimizing your process for the isolation or purification of the target protein.
Protein production and quality control
- Microbiology laboratory offers recombinant protein production services while Bioanalytical laboratory II – Proteomics offers protein quality control throughout the entire proccess – from purification optimization to scale-up.
INSTRUMENTS AND EQUIPMENT
Preparative chromatography systems
- ÄKTA Pure 25, GE Healthcare Life Sciences
- ÄKTA Avant 25, GE Healthcare Life Sciences
- ÄKTA Avant 150, GE Healthcare Life Sciences
- ÄKTA Pilot, GE Healthcare Life Sciences
Tangential flow filtration system
- SARTOFLOW Advanced, Sartorius
Centrifugation equipment and thermostatic room
- Centrifuge, Sorvall Lynx 4000, Thermo Scientific
- Cold room with thermostatically controlled temperature (4-8°C)
Bioanalytical laboratory I (chemistry) staff:
Jasna Jakovljević, Mag. Chem., Senior Associate, e-mail: jasna.jakovljevic@biocentre.hr,
Diana Nejašmić Tušek, M. Eng., Senior Associate, e-mail: diana.nejasmic.tusek@biocentre.hr
Laboratory services:
Development, optimization, transfer and validation of analytical methods for identification and quantification of ingredients. We perform analyses on plant materials, pharmaceutical, food and biotechnological products, as well as on biomedical samples. We use advanced analytical techniques, including spectroscopy, chromatography and mass spectrometry.
Analytical services for plant materials analyses
- Method development and analysis of bioactive components such as natural insecticides, water soluble vitamins, fatty acids, carbohydrates, polyphenols, carotenoids, condensed tannins, total and organic acids, chlorophyll and antioxidative activity by DPPH method
- Aroma profile analysis of plant species and essential oils by gas chromatography coupled with mass spectrometry
- Analyses for different plant parts such as leaves, pulp / fruits, pits or seeds by different extraction methods (e.g. in olives, prickly pear, tangerines, lettuce, beans or strawberries
Analytical services for the pharmaceutical, chemical and cosmetic industries
- R&D analytical support for product development and formulation – analysis of raw materials and development formulations, stability studies during product development, reverse engineering of generic product components and comparison with the originator.
- Development and validation of methods for the quantification of pharmaceutical active substances (API), excipients, preservatives and antioxidants in raw materials, semi-products and finished products, and methods for analyzing the content of active substance residues during the cleaning validation process (rinses and swabs).
- Development and validation of methods, and analysis of the content of volatile impurities with liquid or “headspace” injection. For example, analyzes of alcohol content and impurities in different disinfectants.
- Development and validation of methods, and analysis of the content of impurities caused by the release of contact packaging materials using liquid and/or gas chromatography coupled with tandem mass spectrometry.
Analytical services for biological samples analysis
- Targeted metabolomic analyses of cell lysates and biomass.
- Metabolically non-targeted profiles of compounds formed by the metabolism of various microorganisms.
Analytical services as a part of clinical research
- Targeted analyzes of toxic metabolites in biological fluids.
- Fatty acid profiles in human biological fluids (blood serum).
- Analysis of cryoprotectant residues (dimethyl sulfoxide) and antibiotic residues in physiological solution after washing the tissue and in the tissue itself
Beverage analysis
- Beers (pH, color, bitterness and % alcohol), strong alcoholic beverages (% alcohol and aroma profile), fermented beverages (pH, acidity, sugars, phenols, etc.).
Food analyses
- Analyzes of protein powders (chemical and proteomic analyses).
- Other analyses: acrylamide, biogenic amines in fish and fish products, aroma profiles of meat and meat products.
INSTRUMENTS AND EQUIPMENT
Systems for liquid chromatography
- HPLC-DAD-UV/VIS, Agilent Technologies
- HPLC-RID, Agilent Technologies
- HPLC-FLD, Agilent Technologies
- UPLC-DAD-UV/VIS, Agilent Technologies
Systems for gas chromatography
- GC-FID, Agilent technologies
Systems coupled with mass spectrometry
- UPLC-QQQ-MS/MS, Agilent Technologies
- UPLC-TripleTOF® 6600+ System, Sciex
- GC-MS/MS, Thermo Scientific
Systems for spectroscopy
- Agilent Technologies UV/VIS spectrophotometer
- Agilent Technologies FLD spectrophotometer
Equipment for sample preparation and analysis
- Centrifuge, 21R Digicen
- Rotavapor, Hei-Vap, Heidolph Instruments GmbH
- Nitrogen management system, REACTI-THERM III 18824, Thermo Scientific
- Grinding mill, Tube mill control 100, Ika
- Conductometer, SD30 PURE H2O K, Mettler Toledo
Bioanalytical laboratory II (proteomics) staff:
Vanja Kelava, Mag. Appl. Chem., Senior Associate, e-mail: vanja.kelava@biocentre.hr
Karla Košpić, PhD, Senior Associate, e-mail: karla.kospic@biocentre.hr
Rea Bertoša, M.Eng., Associate, e-mail: rea.bertosa@biocentre.hr
Željka Stanečić, M. Eng., Junior Associate, e-mail: zeljka.stanecic@biocentre.hr
Laboratory services:
Characterization of individual proteins and analysis of complex protein mixtures using both targeted and untargeted approaches. Analysis of higher-order protein structures.

PROTEIN CHARACTERIZATION
Peptide mass fingerprinting or peptide mapping
- Involves protein molecule cleavage using a specific proteolytic enzyme and analysing the resulting peptide mixture using mass spectrometry (MS).
- Analyses can be subjected to direct MS measuring or on-line connected to liquid chromatography (LC-MS).
- Peptide mass fingerprinting can be extended to a protein database search for sequence confirmation or de novo
Molecular weight analysis
- Intact protein molecular weight determination by MS provides accuracy over a wide molecular weight range. Direct MS is used for single protein analysis, and liquid chromatography with MS detection is used for complex mixtures.
- Our gel electrophoresis service offers molecular weight measuring and characterisation of impurities in biopharmaceutical products.
- Additionally, gel electrophoresis can be extended to protein identification through in-gel digestion, followed by MS analysis and database search.
Liquid chromatographic patterns
- We offer a wide range of LC techniques for protein/peptide analysis: size exclusion (SEC), reversed-phase (RP) and ion exchange chromatography (IEX).
- Additionally, following LC separation, we offer MS analysis and protein/peptide identification.
Protein sequencing
- Involves top down sequencing (TDS) and de novo
- TDS provides protein identification through a database search and simultaneous assignment of the N- and C-termini of up to 70 residues from either terminus.
- In de novosequencing for the identification of unknown proteins, the amino acid sequence is deduced without prior knowledge of the DNA or protein sequence. We offer a de novo sequencing service that reveals structural information using fragmentation within a mass spectrometer (LIFT).
Amino acid analysis
- Provides information on the amino acid composition of proteins, peptides and other biological samples containing primary or secondary amino groups within a molecular structure.
- Amino acid analysis allows quantitation of free amino acids, as well as quantitation of amino acids released from macromolecules.
Determination of protein concentration using spectrophotometric and fluorometric assays
- Total protein concentration in biological samples is commonly assessed by spectrophotometric and fluorometric methods, such as the Bradford and Pierce assays.
- For applications requiring high sensitivity and precision at low protein concentrations, the Qubit fluorometric assay is employed, as it minimizes interference from other biomolecules.
Ellman’s test
- Ellman’s test is used to determine the concentration of free thiol groups in proteins by spectrophotometric measurement at 412 nm. The concentration of free thiol groups in the sample is determined using a standard curve containing known concentrations of compounds containing thiol groups, such as cysteine.
PROTEOMICS ANALYSIS
Our liquid chromatography with tandem mass spectrometry detection (LC-MS/MS) services provide targeted and non-targeted proteome analysis.
Non-targeted proteomics
- Our non-targeted proteomics (shotgun proteomics) service, typically involves in-solution or in-gel protein digestion using a suitable proteolytic enzyme.
- The resulting peptides are then separated using nano-LC coupled to a TripleTOF 6600+ mass spectrometer.
- We employ two approaches for generating proteomic data: data-dependent acquisition (DDA) and data-independent acquisition (DIA). The DDA approach is primarily focused on cataloguing proteins from the sample and for building of spectral libraries. On the other hand, the DIA approach is specifically designed for determining changes in protein expression between two or more samples.
Targeted proteomics
- Our targeted proteomics service targets specific peptides in a complex mixture and determines their presence. This analysis usually utilises a triple quadrupole mass spectrometer (QQQ).
- Targeted proteomics is used for verification of knockdown targets, for quantification of a peptide/protein in a complex mixture, and for monitoring changes in abundance of a specific protein across samples or during time-course experiments.
HIGHER ORDER PROTEIN STRUCTURE
Circular dichroism (CD)
- Spectroscopic analysis for protein secondary structure assessment (alpha helix/beta sheets).
EQUIPMENT
Mass spectrometry
- TripleTOF® 6600+ System, Sciex
- MALDI TOF/TOF, Bruker Daltonics GmbH
- LC-(QQQ)-MS/MS, Agilent Technologies
Liquid chromatography
- UHPLC-DAD-UV/VIS, Thermo Fisher Scientific
- HPLC-DAD-UV/VIS, Agilent Technologies
- HPLC-RID, Agilent Technologies
- HPLC-FLD, Agilent Technologies
Spectroscopy
- CD/LD spectropolarimeter, Jasco Europe
Centrifugation equipment
- Mini Centrifuge, mySPIN 12, Thermo Fisher Scientific
- Centrifuge, Centric 200 R, Tehtnica
- Mini-Centrifuge/Vortex Combi-Spin, FVL-2400N, Biosan
Sample preparation equipment
- Concentrator plus, 5305000304, Eppendorf
- Homogeniser, SHM1, Stuart
- Digital Dry Bath, D1200, Labnet
- Digital Heating Shaking Drybath, Thermo Fisher Scientific
Staff:
Željka Hodinj, chem.tech., e-mail: zeljka.hodinj@biocentre.hr
Anita Rustan, bacc.ing.sec., e-mail: anita.rustan@biocentre.hr

Services:
- The Wash and Sterilization Laboratory provides a labware washing service using professional Smeg GW4090C dishwashers. These washers have various programs tailored to the type of labware and the level of soiling. After washing, the labware is dried or sterilized in a Pol-Eko Apparatura dry sterilizer.
- Within the same unit, autoclaving is also offered. This sterilization service uses a Tuttnauer 66120-1 VEP autoclave with a chamber volume of 450 L, as well as mobile Tuttnauer Europe BV 3870 ELDV autoclaves with a volume of 85 L. The autoclaves can be programmed for pressure, temperature, and duration, depending on the material being sterilized.
- In addition to these services, the laboratory performs a critical function in waste disposal. Waste generated in the microbiology and cell biology labs is sterilized by autoclaving. This process reduces hazardous biological waste to a harmless level before it is handed over for further disposal, thereby ensuring the safety of personnel and the environment. This procedure is in compliance with current laws and regulations, as well as the principles of green chemistry, as it prevents the spread of contamination and minimizes the risks associated with handling hazardous waste.
EQUIPMENT
- Laboratory dishwashers, GW4090C & Access, Smeg
- Autoclave, Europe BV, 66120-1, chamber volume 450 L, Tuttnauer
- Autoclave, Europe BV, 3870 ELDV, chamber volume 85 L, Tuttnauer
- Dry sterilizer, SRW 240 STD, Pol-Eko

